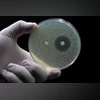

India's alarming superbug surge poses global threat, warns Lancet study
The study highlights alarmingly high levels of antibiotic-resistant bacteria in participants from India, underscoring the need for stronger antibiotic regulation
)
Antibiotic testing in a petri dish, reflecting the surge in drug-resistant infections.(Photo: Adobestock)
Listen to This Article
A new international study published in The Lancet’s eClinicalMedicine has raised alarm over soaring antimicrobial resistance (AMR) in India, placing the country at the centre of what experts describe as a rapidly escalating superbug crisis.
The research, titled 'Preprocedural screening for multidrug-resistant organisms in endoscopic retrograde cholangiopancreatography: an international, multicentre, cross-sectional observational study', found that Indian patients recorded the highest global prevalence of multidrug-resistant organisms (MDROs) among those undergoing a common endoscopic procedure.
What did the Lancet study find?
The study screened more than 1,200 patients across four countries — India, Italy, the Netherlands and the United States.
Among them, 83.1 per cent of Indian patients carried at least one superbug, the highest rate by a large margin.
By comparison:
Also Read
- Italy: 31.5 per cent
- United States: 20.1 per cent
- Netherlands: 10.8 per cent
Experts warn that once such superbugs spread beyond hospitals into communities, treatment options become severely limited or entirely ineffective.
How severe is India’s AMR burden?
India’s results were particularly stark:
- 70.2 per cent carried ESBL-producing bacteria, rendering many common antibiotics ineffective.
- 23.5 per cent had carbapenem-resistant bacteria — resistant even to last-resort drugs. CPE was nearly absent in the Netherlands and rare in the US.
- Several patients were found to carry multiple highly resistant organisms simultaneously.
Researchers say these levels reflect widespread antibiotic misuse, over-the-counter sales without prescriptions and inconsistent infection-control systems.
What risk factors increase likelihood of superbug carriage?
The study identified several conditions associated with higher MDRO prevalence, including:
- Chronic lung disease
- Congestive heart failure
- Recent penicillin use
- Frequent hospital admissions or prior procedures
However, researchers emphasised that these factors cannot fully explain India’s disproportionately high rates, pointing towards a deeper, systemic AMR challenge.
Call for urgent action
Given the stark regional differences, the authors urge countries to adopt localised infection-control strategies rather than one-size-fits-all policies. For India, this may include:
- Using/prescribing antibiotics more carefully and responsibly so they remain effective for longer
- Regulating sales of prescription-only drugs
- Routine preprocedural screening
- Considering single-use devices for high-risk patients to avoid transmission
Public health experts say that without robust intervention, the superbug crisis could undermine decades of medical progress and impact routine surgeries, cancer care and infection management.
More From This Section
Don't miss the most important news and views of the day. Get them on our Telegram channel
First Published: Nov 18 2025 | 5:09 PM IST
